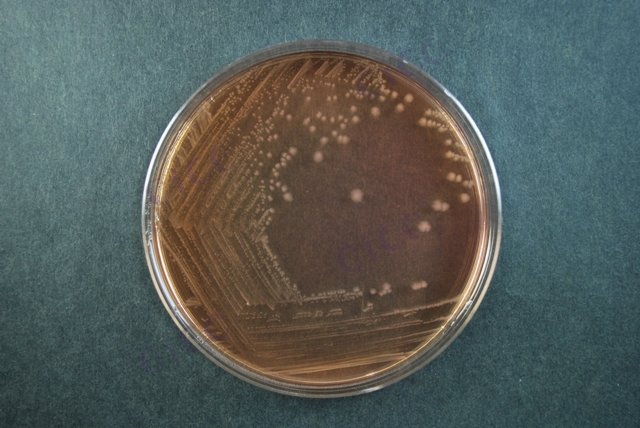
宋内氏志贺氏菌 Shigella sonnei CICC 21535 Shigella sonnei

宋内氏志贺氏菌 Shigella sonnei CICC 21535 Shigella sonnei
-
宋内氏志贺氏菌 Shigella sonnei CICC 21679 Shigella sonnei
CICC 21679 | 见证书
-
宋内氏志贺氏菌 Shigella sonnei CICC 23875 Shigella sonnei
CICC 23875 | 见证书
-
宋内氏志贺氏菌 Shigella sonnei (Levine) Weldin
BNCC361478 | 冻干粉;斜面;菌液;平板
-
宋内氏志贺氏菌 Shigella sonnei (Levine) Weldin
BNCC252669 | 冻干粉;斜面;菌液;平板
-
宋内氏志贺氏菌 Shigella sonnei ATCC 25931 LYFO DISK Shigella sonnei derived from ATCC® 25931™
0303L | 6颗/瓶
-
宋内氏志贺氏菌 Shigella sonnei ATCC 29930 LYFO DISK Shigella sonnei derived from ATCC® 29930™
0350L | 6颗/瓶
-
宋内氏志贺氏菌 Shigella sonnei ATCC 9290 LYFO DISK Shigella sonnei derived from ATCC® 9290™
0446L | 6颗/瓶

说明书下载: 菌种说明书 打管说明书
您正在浏览的产品:宋内氏志贺氏菌 Shigella sonnei CICC 21535
手机版:宋内氏志贺氏菌 Shigella sonnei CICC 21535
本公司销售的所有产品仅供实验科研使用,不用于人体及临床诊断。